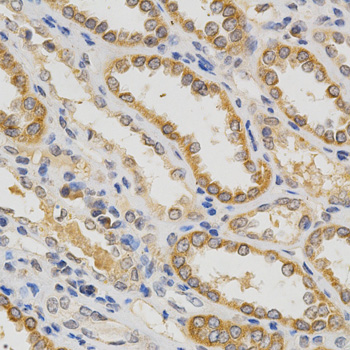
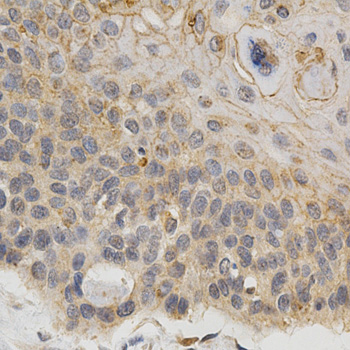

For quotations, please use our online quotation form, and you may also contact us by
service@kendallscientific.com
+1-888.733.6849 (Toll-free)
+1-617.299.7367 (Int’l))
+1-888.733.6849
Our customer service representatives are available 24 hours, Monday through Friday to assist you.| Reactivity | Human |
| Tested applications | WB IHC IF |
| Recommended Dilution | WB 1:500 - 1:2000 IHC 1:50 - 1:200 IF 1:50 - 1:200 |
| Calculated MW | 22kDa |
| Observed MW | Refer to Figures |
| Immunogen | Recombinant protein of human IFNB1 |
| Storage Buffer | Store at -20℃. Avoid freeze / thaw cycles. Buffer: PBS with 0.02% sodium azide, 50% glycerol, pH7.3. |
| Concentration | b |
| Synonym | IFNB1;IFB;IFF; IFNB;MGC96956; |

Western blot analysis of extracts of various cell lines, using IFNB1 antibody.
Immunohistochemistry of paraffin-embedded human kidney using IFNB1 antibody at dilution of 1:200 (x400 lens)
Immunohistochemistry of paraffin-embedded human esophageal cancer using IFNB1 antibody at dilution of 1:200 (x400 lens)

Immunofluorescence analysis of HepG2 cell using IFNB1 antibody. Blue: DAPI for nuclear staining.
The genes encoding type I interferons (IFNs), which include 14 IFN-å genes, one IFN-∫ gene, one IFN-w (also known as IFN-å II1) gene, and a number of IFN-w pseudogenes, are clustered on human chromosome 9. Interferons-å and -∫ are cytokines that are widely known to induce potent antiviral activity. IFN-å and -∫ exert a variety of other biological effects, including antitumor and immunomodulatory activities and are increasingly used clinically to treat a range of malignancies, myelodysplasias and autoimmune diseases. IFN-w is antigenically different from human IFN-å, IFN-∫ or IFN-©, but is a component of natural mixtures of IFN species produced by virus-induced leukocytes or Burkitt's lymphoma cells. The type I interferon receptor (IFN-åR) interacts with IFN-å, IFN-∫ and IFN-w, and seems to be a multisubunit receptor.
N/A